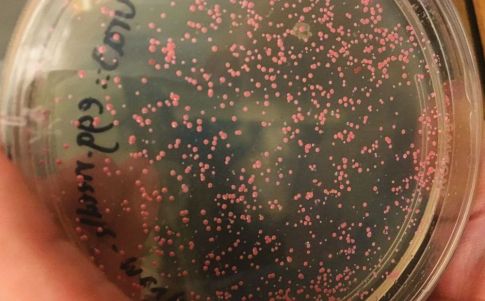
La información fue codificada en el ADN de una cepa de Halobacterium salinarum tolerante a la sal. Foto: JOE DAVIS

HSal, un microbio-mensaje para las civilizaciones futuras
Investigadores pueden crear una cápsula del tiempo, una especie de mensaje que sobreviviría eones para que pudieran descifrarlo civilizaciones futuras. Gracias al ADN de un extraño microbio que vive en depósitos de sal de roca se cree que este «archivo» duraría, puesto que se encuentra protegido por la sal.
Esta idea visionaria es el proyecto de Joe Davis, un artista afiliado a un laboratorio de biología de la Universidad de Harvard. En el estudio, Davis y sus colegas muestran que pueden codificar información en el ADN de Halobacterium salinarum (Hsal), un microbio difícil de matar y tolerante a la sal que tiene, en promedio, 25 copias de respaldo de cada uno de sus cromosomas. Otros investigadores han explorado el potencial de almacenamiento del ADN, que almacena el equivalente a unos 300 megabytes de datos en el núcleo de una célula humana. Además, Davis está combinando esa capacidad con la resistencia de un organismo extraordinariamente resistente.
«Si quieres mantener los datos durante mucho, mucho tiempo, la mejor manera de hacerlo puede ser mantenerlos dentro de las células y utilizar la maquinaria celular para la auto-reparación del ADN», asegura Davis.
Jeff Nivala, un ingeniero biológico de la Universidad de Washington, Seattle, que estudia los halófilos y el almacenamiento de ADN, está de acuerdo. «Si toda la vida es destruida en la Tierra y esto es lo único que queda tal vez esa información podría propagarse por sí misma.»
Las capacidades del microbio
El Hsal puede soportar la desecación, los extremos térmicos, el vacío prolongado y la radiación intensa. Davis incluso lo ha expuesto al óxido de etileno, un gas venenoso utilizado para esterilizar el equipo de laboratorio, sin efectos perceptibles. El Hsal tiene una criptonita: la inmersión en agua dulce hace estallar sus células. Pero cuando se entierra en bolsas salobres dentro de cristales de sal, «podría no morir».
Para aprender más sobre el potencial de los microbios como cápsulas de tiempo, Bisson está estudiando cómo se comportan en los cristales de sal, lo cual «es en gran medida un misterio». En 10 años o más, tiene previsto comparar las cepas de Hsal encerradas en sal con las cepas «madre» o de control conservadas en un congelador para ver si se produce alguna mutación en las cepas de sal presumiblemente más activas. Esos datos ayudarán a llenar un vacío, aunque extrapolarlos a millones de años «sería una exageración», afirma. Bisson también planea utilizar proteínas fluorescentes para averiguar si los organismos permanecen atrapados dentro de las bolsas de salmuera que los sostienen o si se mueven alrededor.
Davis no ha perdido de vista la motivación principal del proyecto que se centra en desentrañar cuestiones hasta filosóficas, como: «¿Qué tipo de legado debería dejar el hombre como especie?». Davis prefiere no responder y por ello planea reunir información de científicos, historiadores, artistas, poetas y filósofos para que lo ayuden a tratar qué se podría incluir en este microbio-mensaje para las generaciones futuras.







Comentarios
Nos interesa tu opinión